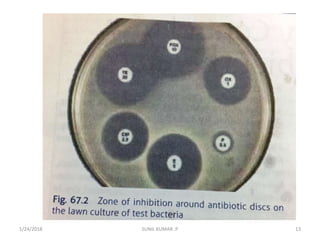
1/24/2018 SUNIL KUMAR .P 13

This document discusses urine culture and sensitivity testing. It describes how microbiological culture is used to multiply microorganisms to determine what types are present in a sample. Sensitivity testing checks the effectiveness of drugs against microorganisms to select the best treatment. Urine culture and sensitivity testing aims to guide treatment selection, control inappropriate drug use, and monitor antimicrobial resistance in a community. It provides details on performing semi-quantitative urine cultures and antibiotic sensitivity testing methods like Kirby-Bauer and Stokes techniques.